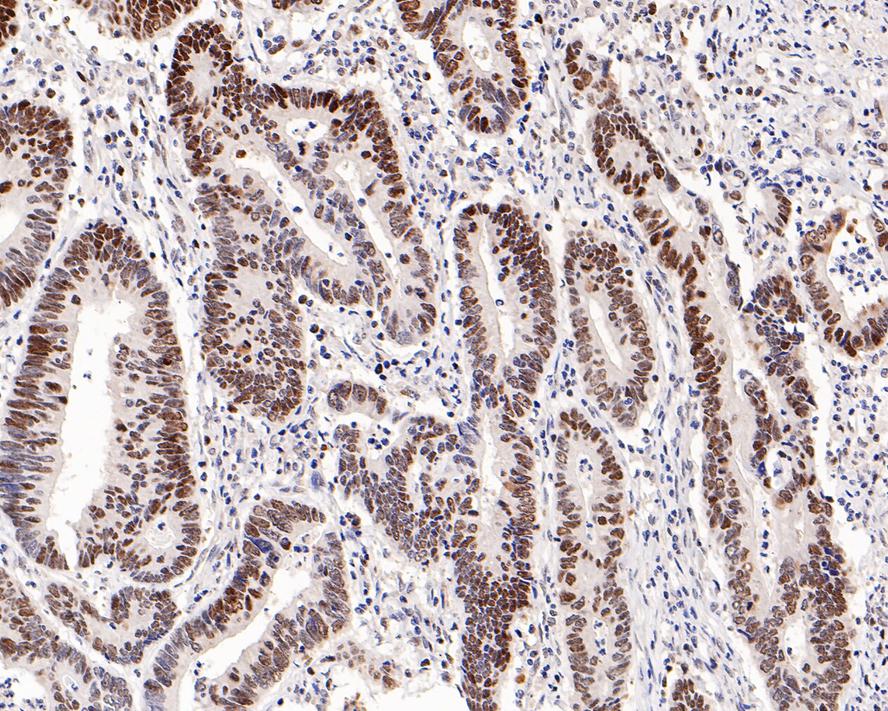

MSH6 Rabbit Monoclonal Antibody(ARA724)
CAT.NO. : ARA6511
RMB Please choose
RMB Please choose
Background
MSH6 is a mismatch repair protein which is deficient in a high proportion of patients with microsatellite instability (MSI-H). It has been suggested that the deficiencies in DNA mismatch repair protein(s) can be seen in some malignancies such as hereditary nonpolyposis colorectal cancer (HNPCC) and endometrial cancer. MSH6 expressed in all proliferating cells participate in repair of base-base mismatch, that occur during DNA replication. Loss of MSH6 expression leads to an accumulation of DNA replication errors in the proliferating cells, particularly in areas of the genome with short repetitive nucleotide sequences, a phenomenon known as microsatellite instability (MSI). MSH6 always used as panel with MLH1, MSH2, PMS2, and may be useful to aid in identifying the most probable gene responsible for the MSI.
Application
|
Application |
Dilution Ratio |
|
WB |
1:200-1:1000 |
|
IHC-P |
1:200-1:1000 |
Overview
|
Antibody Type |
Recombinant Rabbit monoclonal Antibody |
|
Immunogen |
Synthetic peptide within Human MSH6 aa 350-450 (internal sequence). |
|
Species Reactivity |
Human, Mouse, Rat |
|
Validated Applications |
WB, IHC-P, IF-Cell, IF-Tissue |
|
Molecular Weight |
Predicted band size: 153 kDa |
|
Positive Control |
A549 cell lysate, HepG2 cell lysate, human tonsil tissue, human colon carcinoma tissue, human stomach carcinoma tissue, mouse small intestine tissue. |
|
Conjugation |
unconjugated |
|
Form |
Liquid |
|
Storage Buffer |
PBS (pH7.4), 0.1% BSA, 40% Glycerol. Preservative: 0.05% Sodium Azide. |
|
Isotype |
IgG |
|
Purification Method |
Protein A affinity purified. |
Data

Immunohistochemical analysis of paraffin-embedded human tonsil tissue with MSH6 Rabbit Monoclonal Antibody(ARA724).

Immunohistochemical analysis of paraffin-embedded human colon carcinoma tissue with MSH6 Rabbit Monoclonal Antibody(ARA724).
Storage
Store at 4°C short term. For long term storage, store at -20°C, avoiding freeze/thaw cycles.
Research Use Only
For Research Use Only. Not for use in diagnostic procedures.
 New Products
New Products